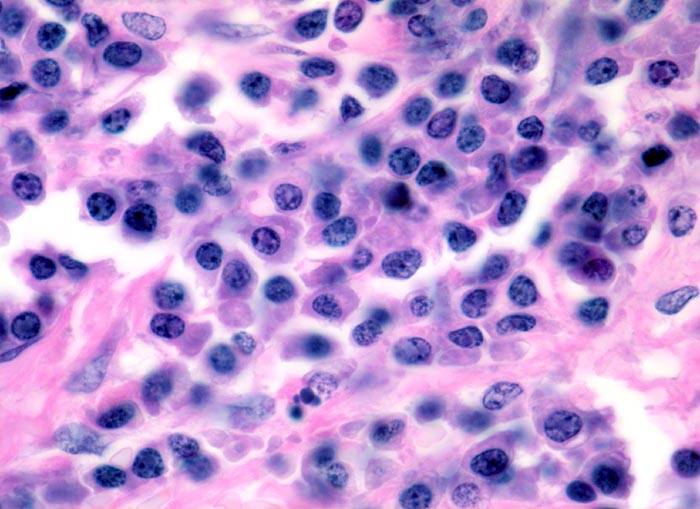

PathoPic – image database / PathoPic ID 4163 - Plasmazellmyelom
de
Diagnose
Plasmazellmyelom
Diagnose Gruppe
maligner Tumor
Topographie
Knochenmark, Wirbelkörper
Topographie Gruppe
Lymphatische Gewebe, KM, Milz
Beschreibung
Klinik
Notfalleinweisung wegen umschriebenen Thoraxschmerzen ohne adäquates Trauma. Im Röntgenbild Nachweis multipler Frakturen der Wirbelsäule und der Rippen bei grobsträhniger Osteoporose. In der Serumelektrophorese Nachweis einer Paraproteinämie.
Bilder Typ
Histologie
Vergrösserung
630
Alter
64
Geschlecht
männlich
Datum
Ersteintrag: 04.03.2002
Update: 09.09.2013